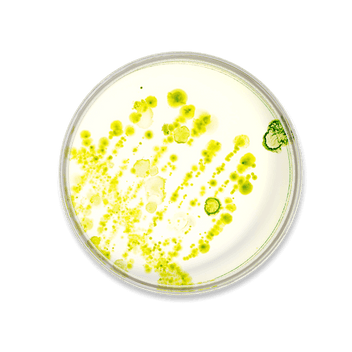

proba gluco metabolism PRO
proba gluco metabolism PRO
- Drog- och hormonfritt alternativ för metabolt stöd
- Innehåller ingredienser som är kopplade till aptitreglering och mättnadskänsla
- Innehåller komponenter som är kopplade till kolhydrat- och sockerabsorption, vilket stödjer metabolisk balans
- 60 kapslar per förpackning
- Vetenskapligt underbyggd formelMed Lactobacillus paracasei D3-5, Reducose®, berberin, krom och cikoria
- Snabbverkande:Kliniskt bevisat att det fungerar inom några minuter i din kropp
Köp mer, spara mer!




Det gick inte att ladda hämtningstillgänglighet
-
Gratis frakt över 300 kr
-
Leverans inom 1-3 arbetsdagar
-
100 dagars öppet köp














proba gluco metabolism PRO
-
Hormonfri
-
Inget gluten
-
Icke-GMO
-
Ingen fruktos
-
Vegansk
-
Inget socker
Innehåll som kan döljas
Ingredienser
Indisk berberis (Berberis aristata DC.) rotextrakt med 97% berberinhydroklorid, vit mullbär (Morus alba L.) bladextrakt,hydroxipropylmetylcellulosa (kapselskal), majsstärkelse, majssfiber, Lactobacillus paracasei D3.5 HI (värmeinaktiverade celler),cikoriarot (Cichorium intybus L.) extrakt med 20% inulin, klumpförebyggande medel: magnesiumsalter av fettsyror, krompikolinat.
Bruksanvisning
Vuxna bör ta 2 kapslar dagligen med mycket vatten utan att tugga.
Viktiga anmärkningar
Den angivna rekommenderade dagliga dosen bör inte överskridas. Kosttillskott är inte ett substitut för en balanserad och varierad kost samt en hälsosam livsstil. Förvara produkten skyddad från ljus, på en sval och torr plats. Förvaras oåtkomligt för små barn.
Metaboliskt stöd

Metaboliskt stödMetaboliska processer är beroende av naturliga föreningar som produceras i kroppen, och som spelar en roll i matsmältning, blodsockerreglering och aptitsignaler. Faktorer som åldrande och livsstil kan påverka dessa processer.
Proba gluco metabolism PRO innehåller ingredienser som är kopplade till att stödja dessa naturliga funktioner och bibehålla en balanserad ämnesomsättning. Formeln stödjer även tarmmikrobiomets hälsa med cikoria och fördelaktiga bakterier, vilket bidrar till matsmältning och underhåll av tarmens slemhinna.
Kliniskt bevisat att det fungerar inom några minuter i din kropp.
-
65%Ökning av specifika naturliga föreningar
-
-42%Stödjer upprätthållandet av sunda blodsockernivåer
-
-41%Bidrar till balanserad insulreglering
Hur kroppens naturliga processer fungerar
- 1När du äter aktiverar din kropp metaboliska vägar genom tarm-hjärnans koppling. Näringsämnen i matsmältningskanalen signalerar frisättningen av specifika föreningar som är involverade i aptitreglering.
- 2Dessa föreningar går in i blodomloppet och interagerar med olika organ, särskilt bukspottkörteln.

- 3De binder till receptorer på bukspottkörtelns beta-celler, främjar insulinfrisättning, reglerar aptiten och påverkar hastigheten på matsmältningen.
- 4Dessa naturliga processer hjälper dig att känna dig mätt och stödjer en hälsosam glukosmetabolism. Faktorer som ålder, livsstil och kost kan dock påverka hur effektivt din kropp utför dessa funktioner – här är det vi kan hjälpa till med.
Våra noggrant utvalda ingredienser

Garanterad hög potens
För att säkerställa hög potens av våra bioaktiva ingredienser använder vi specialiserade Activ-Vial™-burkar med ett aktivt polymerfoder som effektivt absorberar fukt och bevarar ingrediensernas stabilitet.
FAQ
-
Hur ska jag ta det?
Ta 2 kapslar dagligen med vatten, utan att tugga. Överskrid inte den rekommenderade dosen.
-
Hur länge ska jag ta det?
Proba gluco metabolism PRO är designad som ett dagligt kosttillskott och kan användas på lång sikt.
-
Vilka ingredienser ingår?
De viktigaste komponenterna är: Värmeinaktiverade bakteriestammar för tarmhälsa Reducose® (250 mg), som stödjer kolhydratmetabolismen Berberin (250 mg), kopplat till balanserat blodsocker Krom (6 mcg), som stödjer makronäringsämnesmetabolismen Cikoria (20 mg), förknippat med matsmältning och leverfunktion
-
Är det lämpligt för kostrestriktioner?
Ja, det är glutenfritt, fruktosfritt, icke-GMO, veganskt och innehåller inget socker.
-
Kan jag ta det med andra mediciner?
Rådfråga din vårdgivare innan du börjar med något nytt kosttillskott, särskilt om du är på medicin eller har hälsoproblem.
-
Kan jag ta det om jag är gravid?
Proba gluco metabolism PRO har inte specifikt studerats under graviditet eller amning. Rådfråga din vårdgivare innan användning.
-
Finns det några biverkningar?
Vissa användare kan uppleva milda matsmältningssymtom under de första 14 dagarna, såsom gaser, uppblåsthet eller lös avföring. Om symtomen kvarstår, avbryt användningen och rådfråga din vårdgivare.
-
Kan denna produkt ersätta en hälsosam kost?
Nej, detta kosttillskott är inte ett substitut för en balanserad kost och en hälsosam livsstil.

Hur kan vi hjälpa dig?
-
E-post till info@nupureshop.com
-
Ring 05-45 52 25 70
Håll dig uppdaterad
Exklusiva specialerbjudanden, produktlanseringar och de senaste vetenskapliga upptäckterna levereras alltid till din inkorg.
- När du gör ett urval uppdateras sidan.
- Öppnas i ett nytt fönster.